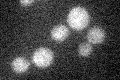
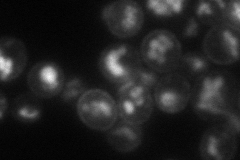
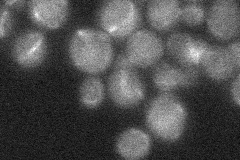

View description
Protein of unknown function, involved in the proteolytic activation of Rim101p in response to alkaline pH; has similarity to A. nidulans PalI; putative membrane protein
Localization:
Intensity:
Fold change:
Significance:
-
C’ GFP library in SD
below threshold18.47 -
N' NOP1pr-GFP in SD

punctate35.2953 -
N' TEF2pr-mCherry in SD
cell periphery,vacuole66.2744 -
N' NATIVEpr-GFP in SD
below threshold19.083 -
N' TEF2pr-VC and Cyto-VN in SD

below threshold23.0828 -
C’ GFP library in SD+DTT

cytosol17.370.94No -
C’ GFP library in SD+H2O2

cytosol14.830.8No -
C’ GFP library in Starvation Media

cytosol18.160.98No -
C’ GFP library on the background of Pup2-DaMP

below threshold -
C’ GFP library on the background of CCT mutant

below threshold20.63591.11723No
